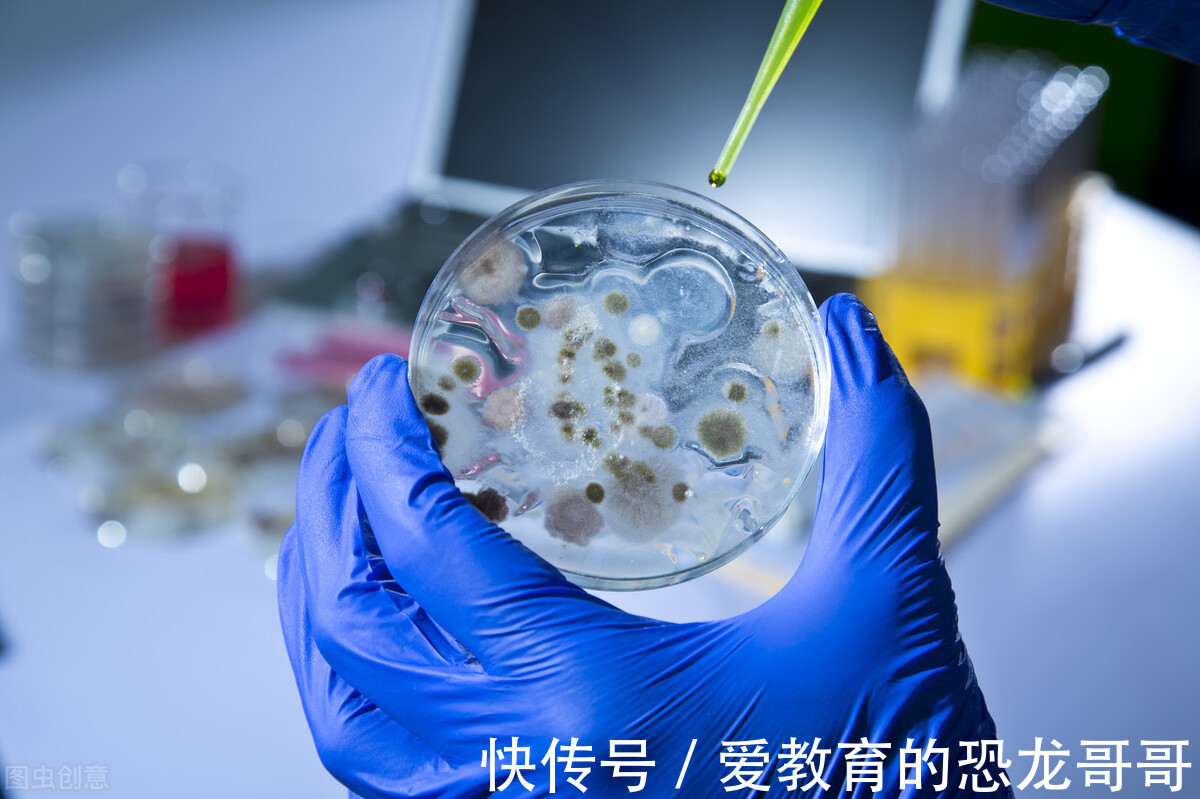

走进洁厕灵的化学世界,我来教你分析其中的化
【作者】网站采编
【关键词】
【摘要】小朋友们有没有有没有看过妈妈打扫卫生间呢?那妈妈是如何做的呢?走进卫生间我们仔细观察,原来妈妈也需要好帮手,今天我们就来认识一下吧! 1.?洁厕剂 洁厕剂又叫洁厕宝,洁
小朋友们有没有有没有看过妈妈打扫卫生间呢?那妈妈是如何做的呢?走进卫生间我们仔细观察,原来妈妈也需要好帮手,今天我们就来认识一下吧!
1.?洁厕剂
洁厕剂又叫洁厕宝,洁厕灵,洁厕液,是一种清洁、杀菌、消毒厕所马桶的清洁用品。
洁厕剂按其配方组成不同大致可分为三大类:酸性产品;中性产品;碱性产品。市场上以酸性产品为主,清洗效果最佳。洁厕剂是专门为厕盆内的顽固污渍而特别设计,能迅速有效地分解厕盆内的顽固污垢,无须费力擦洗;更有杀菌功效,清洁的同时还能杀灭盆内隐藏的细菌,光亮且不损伤厕盆表面。

目前市面上的洁厕剂按形态分主要有酸性产品;中性产品;碱性产品两大类,固体洁厕剂也叫洁厕宝,液体洁厕剂称为洁厕液。洁厕宝的使用方法是:只需要将其投入马桶的水箱,洁厕宝溶于水中,在每次冲水的时候就能达到清洁马桶的功效。洁厕液的使用方法则是:将洁厕液直接喷洒在马桶表面,停留5-8分钟,再以刷子刷洗后,用清水清洗即可亮丽如新。

洁厕剂是由表面活性剂、高效杀菌剂及其他洗涤助剂经过科学调配而成的清洁产品。其特点有:
1) 去除抽水马桶的污物(包括水箱的边缘,内侧等),达到最佳清洁效果;
2) 保持瓷体不受腐蚀,保持表面光泽;
3) 消毒杀菌,并抑制细菌的繁殖;
4) 迅速除臭,保持空气清新。
2.洁厕剂与84消毒剂的区别
目前的洁厕灵主要是酸性洗涤剂,主要成分是盐酸(HCl);84消毒液是碱性洗涤剂,主要成分是次氯酸钠(NaClO);二者结合,产生具有强烈刺激性气味的有毒气体---氯气。氯气是一种有毒气体,易挥发,如果中毒了,轻者可能引起咳嗽、胸闷等,重者可能出现呼吸困难。因此,清洁马桶时,应该将这两种物品分开用。
需要注意的是,消毒剂只有在一定的浓度下才有消毒效果,浓度不够不但达不到消毒效果,更是培养了“毒物”的“耐药性”时间一长,就会对顽固的细菌无可奈何,而浓度太高会对消毒对象产生破坏作用,并对人们健康带来危害。因此,1000mL的水里放5--8mL消毒液就足够了,如果是对物品进行消毒,浸泡时间应该在二十分钟以上,盖上盖子,以防有效成分氯挥发。

3.洁厕剂的成分功能
洁厕剂主要有清洁、杀菌和消毒的功能。通常尿碱的主要化学成分有:无机物部分有磷酸盐,有机物部分主要是尿素、各种蛋白质及氨基酸残基。白醋、柠檬酸与尿碱发生化学反应,作为除垢剂,小苏打具有超强的清洁能力,一定浓度的双氧水可以达到消毒,灭菌的效果。

4、课外拓展
使用洁厕剂的注意事项:
1) 许多洁厕剂主要是靠盐酸来达到去除尿碱的作用的,而盐酸具有很强的腐蚀性,所以使用洁厕剂时应尽量避免接触皮肤。万一将洁厕剂洒到了皮肤上,可用清水进行冲洗。
2) 由于洁厕剂一般都具有腐蚀性,所以洁厕剂不能用于非瓷表面,如木地板、水泥地、大理石及铝制品。
3) 洁厕剂不能与其他洗涤用品同时使用。
文章来源:《化学与粘合》 网址: http://www.hxyzhzz.cn/zonghexinwen/2021/0918/505.html
上一篇:应如何增强诗词内涵?这5种布局风格变化学会后
下一篇:化学物质泄漏 造成2死多伤